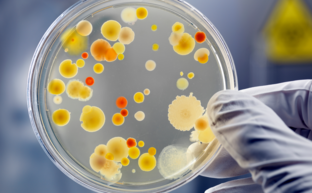

Wasseranalyse
Mit der Wasseranalyse können Sie prüfen, ob die Qualität Ihres Trinkwassers gut ist. Durch Multielement-Analysen und mikrobiologische Analysen, werden potenzielle Verunreinigungen oder Ungleichgewichte herausgefunden. Anschließend können geeignete Maßnahmen zur Sicherstellung der Wasserqualität ergriffen werden.
Was wird bei der Wasseranalyse untersucht?

Multielement-Analyse
Die Multielement-Analyse ist eine hochmoderne Methode zur Untersuchung von Wasserproben auf das Vorhandensein verschiedener Elemente und Verbindungen. Durch die Analyse von Parametern wie Schwermetalle, Mineralstoffe und anderen chemische Bestandteile können potenzielle Risiken für die Gesundheit erkannt und geeignete Gegenmaßnahmen empfohlen werden. Diese Analysen helfen dabei, sicherzustellen, dass das Trinkwasser den geltenden Gesundheitsstandards entspricht und für den menschlichen Verzehr sicher ist.
Mikrobiologische Analysen
Parallel dazu werden mikrobiologische Analysen durchgeführt, um das Wasser auf das Vorhandensein von Mikroorganismen wie Bakterien, Viren und Protozoen zu untersuchen. Diese Organismen können potenziell gesundheitsschädlich sein und Krankheiten wie Durchfall, Magen-Darm-Infektionen und andere Erkrankungen verursachen. Durch mikrobiologische Analysen können potenzielle Kontaminationsquellen identifiziert und geeignete Desinfektions- oder Reinigungsmaßnahmen empfohlen werden, um die Sicherheit des Trinkwassers zu gewährleisten.
Professionelle Durchführung der Wasseranalyse
Die Wasseranalyse wird von qualifiziertem Fachpersonal durchgeführt, das über fundiertes Wissen und modernste Instrumente verfügt, um genaue und zuverlässige Ergebnisse zu liefern. Sie können Wasserproben aus verschiedenen Quellen wie Leitungswasser oder Brunnenwasser zur Analyse in die Apotheke bringen. Aufgrund der Bedeutung von sauberem und gesundem Trinkwasser ist die Wasseranalyse eine Dienstleistung, die sowohl von Privatkunden als auch von Unternehmen und öffentlichen Einrichtungen in Anspruch genommen wird.
Durch die Kombination von Multielement-Analysen und mikrobiologischen Analysen bieten die MEDICON Apotheken eine umfassende Überwachung und Beratung zur Sicherstellung der Wasserqualität.
Jetzt einfach vorbeikommen!
Kommen Sie in Ihre nächstgelegene MEDICON Apotheke und fragen Sie nach der Wasseranalyse.
